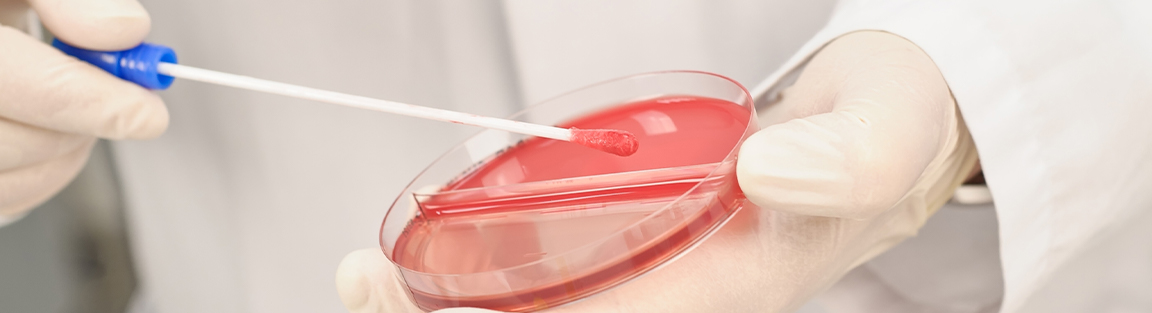

Labor Saarbrücken
Brücken verbinden. Zum Beispiel die Alte Brücke, St. Johann mit Alt-Saarbrücken.
Auch in der Medizin nehmen Brücken eine verbindende Funktion ein.
Wir verbinden für Sie alle labormedizinischen Fachbereiche miteinander, so dass Sie bei uns alles aus einer Hand bekommen.
Wir unterstützen das Klinikum der Maximalversorgung sowie fast 200 Praxen, mehrere medizinische Versorgungszentren und externe Kliniken in der Region mit Labordiagnostik. Und das rund um die Uhr. Damit sind wir eines der wenigen Labore in Deutschland, das Krankenhäuser wie auch niedergelassene Ärztinnen und Ärzte mit Routine- und Spezialdiagnostik versorgt. Daraus ergeben sich Vorteile:
- Krankenhäuser greifen auf ein weites Analysenspektrum zu
- Praxen profitieren von der Notfallversorgung außerhalb gewöhnlicher Dienstzeiten – 365 Tage im Jahr.
Dabei genießen alle die Vorzüge eines regionalen Labors mit persönlicher und individueller Betreuung, verbunden mit der Leistungsfähigkeit der Bioscientia.
Als regionales Labor der Bioscientia betreuen wir Praxen und Kliniken im Saarland und dem südlichen Rheinland-Pfalz mit Parametern des gesamten Laborspektrums. Dazu gehören:
|
Hämatologie |
Gerinnung |
Klinische Chemie |
|
Hormonuntersuchungen |
Tumormarker |
Infektionsserologie |
|
Blutgruppenserologie/Immunhämatologie |
Mikrobiologie |
|
Entdecken Sie unser komplettes Diagnostik-Angebot.
Wir bieten die Facharztweiterbildung in Laboratoriumsmedizin und Mikrobiologie, Virologie und Infektionsepidemiologie an. Entdecken Sie offene Stellen bei Bioscientia.
Bioscientia Labor Saarbrücken | Winterberg 1, 66119 Saarbrücken | +49 681 8837 91-33
Ärztliche Laborgemeinschaft Völklingen
Tel.: +49 681 8837 91-33 | Fax: +49 681 8837 91-42 | labor-saarbruecken@bioscientia.de
Öffnungszeiten: Montag bis Freitag: 08:00 bis 19:00

